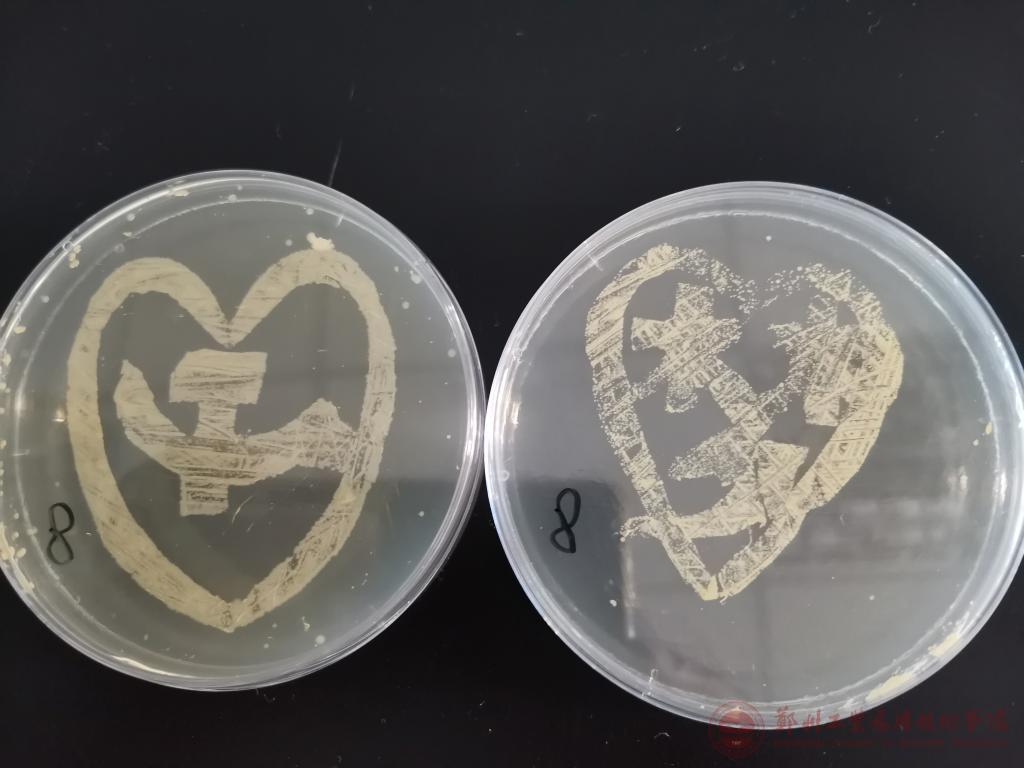

2021年6月2日至6月10日,beat365微生物与免疫学教研室在医学楼南405室进行了第五届形态学技能大赛,此次比赛的参赛选手包含2020级护理专业和2020级康复治疗学专业的同学。本次形态学技能大赛分为初赛和决赛两个部分,初赛比赛内容为细菌的形态学观察,考查选手的显微镜使用熟练程度和细菌形态结构的的掌握程度。决赛的比赛内容为细菌密集划线接种技术和紫外杀菌实验,最终细菌造型要求主题为"中国共产党成立100周年"。经过激烈的角逐,来自2020级护理9班的张博同学以其作品“梦”获得第一名。
2021年6月16日,beat365副经理何群力教授为各位获奖选手颁发奖状和奖品。本次比赛融入了课程思政元素,进行党史学习教育的同时,既提高了各位参赛同学的创新能力,又培养了科研意识。